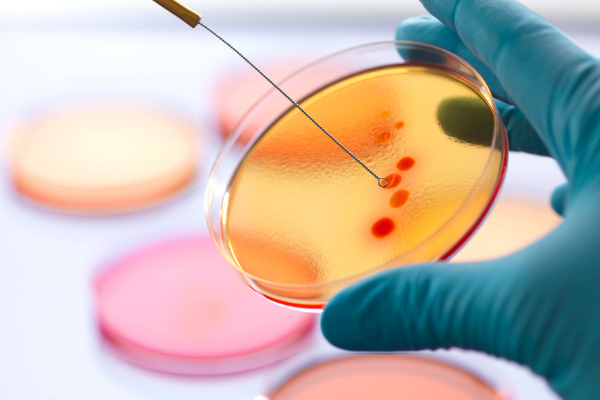

Microbiología
Servicio de Microbiología
Un tratamiento correcto de las infecciones bacterianas comporta el reconocimiento de su agente causal y su eventual sensibilidad a ciertos antibióticos con ello se puede facilitar al veterinario practico el establecimiento temprano de una terapéutica etiológica.
Servicio
-
Hemocultivo
Sangre EDTA
-
Urocultivo
Orina
-
Urocultivo – con recuento de colonias y antibiograma
Orina
-
Coprocultivo + antibiograma
Materia fecal
-
Cultivo de secreciones + antibiograma
Secreciones
-
Cultivo de hongos
Pelo y Frotis de la lesión
-
Cultivo de anaerobios (solo)
Medio de transporte
-
Cultivo de anaerobios + antibiograma
Medio de transporte
-
Cultivo para gérmenes comunes
Medio de transporte
-
Células somáticas
Leche
-
Unidades formadoras de colonia
Leche
-
Nitrógeno ureico en leche (MUN)
Leche
-
Cultivo para gérmenes comunes + antibiograma
Medio de transporte
-
Cultivo campylobacter y trichonomas
Lavado prepucial
-
Análisis microbiológico de agua
1 L de agua
-
Análisis microbiológico de alimentos
Alimento
-
Análisis fisicoquímico de agua
1 L de agua
-
Análisis microbiológico de leche
Leche
-
Análisis fisicoquímico de molibdeno
Suelo
-
Análisis fisicoquímico de suelo
2 KL de suelo
-
Bromatología de pasto
Pasto
Cultivo y antibiograma leche
-
Cultivo leche, antibiograma leche
Leche
$55.000
Hemocultivo y antibiograma
-
Hemocultivo, antibiograma desde hemocultivo
Sangre sin anticoagulante
$60.000











